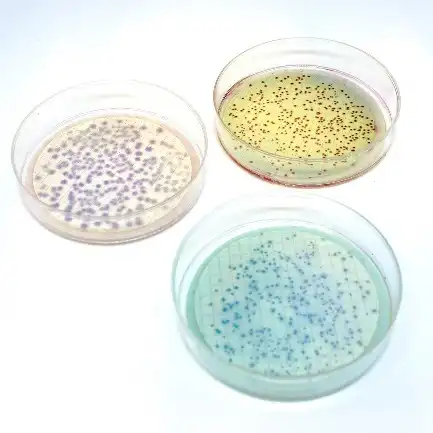
Membran filtrasyon besiyerleri
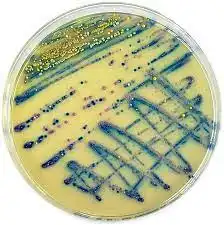
Kromojenik besiyerleri

Liofilchem® Mikrobiyolojik Ürünlerde Uzmanlık ve Küresel Güvenilirlik
1983 yılından bu yana faaliyet gösteren Liofilchem, güvenilir ve yüksek kaliteli mikrobiyolojik ürünlerin geliştirilmesi ve üretimi konusunda uzmanlaşmıştır. Antimikrobiyal direncin küresel ölçekte yayılımına karşı mücadelede aktif rol almakta; bu amaçla, önde gelen uluslararası ilaç firmalarıyla iş birliği içinde antimikrobiyal duyarlılık testlerine yönelik tanı sistemleri tasarlamaktadır.
Geliştirilen ürün portföyünde MTS™ (Minimum İnhibitör Konsantrasyon Test Şeridi), antibiyotik diskleri, broth mikrodilüsyon ve agar dilüsyon panelleri, hızlı fenotipik testler ve kromojenik kültür ortamları yer almaktadır.
Ayrıca üretim gamı; dehidre ve kullanıma hazır besiyerleri, biyokimyasal tanımlama panelleri, çevresel örnekleme ekipmanları, sterilizasyon süreçleri için biyolojik indikatörler, liyofilize mikroorganizmalar ve manuel fenotipik mikrobiyolojiye yönelik çeşitli çözümleri kapsamaktadır.
Üretim ve Kalite Sistemleri
Liofilchem ürünleri, dünya genelinde 150’den fazla ülkede klinik ve endüstriyel laboratuvarlarda kullanılmaktadır. Tüm üretim, kalite kontrol ve Ar-Ge süreçleri, İtalya'nın Roseto degli Abruzzi kentinde bulunan ve toplamda 20.000 m²’yi aşan dört tesiste yürütülmektedir. Üretim ortamı, GMP prosedürlerine uygun olarak A sınıfı temiz oda koşullarında gerçekleştirilmekte ve sıkı partikül ile mikrobiyolojik kontrollerle denetlenmektedir.
Sertifikasyon ve Uyum
Liofilchem, ISO 9001 kalite yönetim sistemi ile ISO 13485 in vitro tanı cihazları üretim sertifikalarına sahiptir. Tüm üretim süreçleri, ISO standartları, Avrupa IVDR düzenlemeleri ve ABD FDA gereklilikleriyle tam uyum içinde yürütülmektedir.